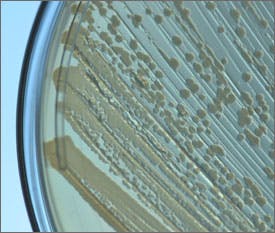

Engineered E. coli mass-produce key precursor to potent biofuel
New lines of engineered bacteria can tailor-make key precursors of high-octane biofuels that could one day replace gasoline, scientists at the Wyss Institute for Biologically Inspired Engineering at Harvard University and the Department of Systems Biology at Harvard Medical School report in the June 24 online edition of Proceedings of the National Academy of Sciences.
The same lines can also produce precursors of pharmaceuticals, bioplastics, herbicides, detergents, and more.
"The big contribution is that we were able to program cells to make specific fuel precursors," said Pamela Silver, Ph.D., a Wyss Institute Core Faculty member, Professor of Systems Biology at Harvard Medical School, and senior author of the study.
New biofuels are needed for cars and other vehicles. Ethanol, the most popular biofuel on the market, packs only two-thirds the energy of gasoline, and ethanol-containing fuels also corrode pipes, tanks, and other infrastructure used to transport and store gasoline. Meanwhile, burning gasoline itself adds huge amounts of carbon dioxide to the atmosphere, and relies on the world’s dwindling supply of oil.
Yet gasoline produces more energy than current biofuels when burned in an internal combustion engine, and remains liquid in temperatures ranging from a Texas heat wave to a North Dakota cold snap. Moreover, hundreds of millions of cars worldwide are built to run on it.
Silver and her team are seeking new ways to make gasoline-like biofuels that could be stored at gas stations and used to fuel the cars we already have. To develop these, they enlisted the iconic laboratory bacterium E. coli to help make gasoline precursors called fatty acids — energy-packed molecules containing chains of carbon atoms flanked with hydrogen atoms that can be easily converted into fuels.
Specifically, they are focusing on medium-chain fatty acids — those with chains between four and 12 carbons long. Fatty acids with shorter chains do not store enough energy to be good fuels and they tend to vaporize easily, while those with chains longer than 12 carbons are too waxy. But medium-length fatty acids are just the right length to be transformed into an energy-packed liquid fuel for internal-combustion engines.
Today oil refineries produce medium-chain-length compounds from crude oil. But "instead of using petroleum products, you can have microbes or other living organisms do it for you," Silver said.
To accomplish that, Joe Torella, Ph.D., and Tyler Ford, Harvard Medical School Systems Biology graduate students in Silver’s laboratory and the paper’s lead coauthors, tweaked an E. coli metabolic pathway that produces fatty acids. Specifically, they mass-produced an eight-carbon fatty acid called octanoate that can be converted into octane.
In this pathway, carbon from sugar, which the bacterium eats, flows through the pathway like a river, growing longer as it flows. Downstream, it exits as a long-chain fatty acid.
Torella and Ford first partially dammed the river and built an irrigation ditch using a drug that blocks enzymes that extend fatty-acid chains. This caused medium-chain fatty acids to pool behind the dam, while still allowing enough of the river to flow by for the bacteria to build their membranes and stay alive. The strategy increased octanoate yields, but the drug is too expensive for the process to be scaled up.
For that reason, the scientists tried a second strategy that could be scaled up more readily. They let the cells grow up, then dammed the river using a genetic trick. They also genetically altered a second enzyme that normally builds long-chain fatty acids such that it extends fatty acids to eight carbons and no longer.
This two-pronged strategy — plus some other genetic nips and tucks to keep the river from being diverted in other ways — gave the scientists the highest yields of octanoate yet reported.
"We found if we stop up the river — if we slow fatty acid elongation — we encouraged the creation of medium-chain fatty acids," Torella said.
"Sustainability is one of the biggest problems we face today, and developing potent biofuels to replace gasoline is a major challenge in the field," said Don Ingber, M.D., Ph.D., Wyss Institute Founding Director. "Using ingenious synthetic-biology strategies to engineer microbes so that they can produce octane, Pam’s team has taken a giant step toward meeting this challenge."
Next, the scientists plan to engineer E. coli to convert octanoate and other fatty acids into alcohols, potential fuel molecules themselves, and just one chemical step away from octane.
This work was funded by the Department of Energy’s Advanced Research Project Agency-Energy (ARPA-E) and by the National Science Foundation. In addition to Silver, Torella, and Ford, the research team included Scott Kim and Amanda Chen, students on Silver’s team, and Jeffrey Way, Ph.D., a Senior Staff Scientist at the Wyss Institute.